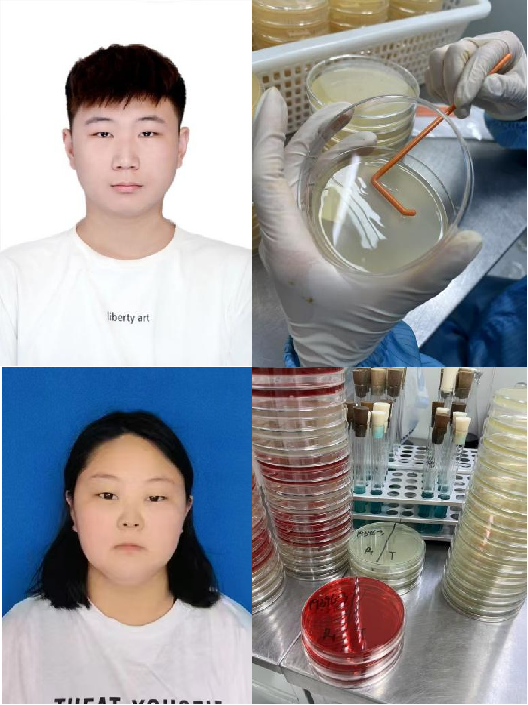

(通讯员 海丹)2025年6月16日,百合小说
23名22级食品营养与健康专业本科生在海丹、李占超老师带领下,赴华测检测认证集团股份有限公司开展为期4周的生产实习。企业食品检测部主管李冬峰、营销经理王恩飞热情接待师生团队,首日即安排食品安全检测理论课程,系统讲解理化分析、微生物检测及样品前处理等核心技术,随后学生按专业方向分配至对应实验室,参与农药残留筛查、微生物菌群鉴定等实战项目,实现课堂与岗位的无缝衔接。
6月26日,学院院长黄现青、系主任高晓平、党支部书记雷萌萌赴企业慰问实习学生并开展“访企拓岗”行动。黄现青强调,
华测检测作为国内第三方检测标杆企业,技术实力与行业视野与学院人才培养目标高度契合,期待共建长效合作机制。华测总经理李俊超(河南农大校友)表示,企业始终重视产学研协同,愿为学子提供实践平台,并期待在检测技术创新、行业标准制定等领域深化合作。
此次合作不仅拓展了学生就业渠道,更推动人才培养与行业需求精准对接。学院将基于企业反馈优化课程体系,华测则计划设立“农大专项实习岗”,双方拟联合申报食品营养与安全领域科研课题,为行业发展注入创新动能。
实习期间,学生深度参与真实检测流程,纷纷表示企业导师指导仪器操作,让学生们真正理解了《食品分析》、
《仪器分析》等课程的理论价值。
2022级食品营养与健康一班李海涛同学:在华测的实习过程中,我最深刻的体会是“现场第一时间掌握问题”的重要性。与其说是在公司学习技术,不如说是在学习如何观察、思考和处理细节。我跟着公司微生物部管理货物的员工进行了货物编码与整理,过程虽然琐碎,但通过不断追溯原料、工艺参数和操作记录,真正理解了数据化管理背后的控制逻辑。相比课堂上标准化的流程讲解,这种一线数据带来的反馈更直观,也更贴近真实生产。此前在学校学习的微生物学、食品安全、实验室管理等课程,在实习中得到了大量验证和应用。我也慢慢意识到,在公司工作讲求效率、执行、协作,而非单纯的知识积累;食品安全检测并不只是靠标准书,而是靠每一处细节的执行力。此次实习让我体验了从“学生”到“职业人”的视角转变,在未来入职后,这种来自底层的感知力或许才是最有价值的资本。
2022级食品营养与健康二班贺舒方同学:在华测检测公司为期一个月的实习中,我有幸加入有机二组,担任样品前处理岗位的工作。样品前处理包括样品的称量、萃取、净化等操作,其质量直接影响后续检测结果的准确性。通过系统的培训和实践,我逐步掌握了前处理的核心技术要点,确保每份样品都能符合实验室分析的标准要求。在带教老师指导下,我熟练掌握了不同类别样品(如食品、农产品等)的前处理方法。例如,针对动物组织样本,需通过匀浆、离心、液液萃取等步骤去除杂质,提取目标待测物。操作中严格遵循国家标准,控制温度、时间、试剂配比等参数,确保实验的可重复性和数据可靠性。通过参与实际检测项目,我深刻认识到兽药残留(如抗生素、激素类药物)对食品安全的重大影响。残留超标可能导致人体耐药性增强、内分泌紊乱等健康问题。而检测技术的精准性,不仅是企业合规生产的保障,更是维护市场秩序、守护公共卫生安全的重要防线。本次实习是我从理论学习到实践应用的重要桥梁。未来,我将以此次实习为起点,持续夯实专业基础,关注行业前沿技术,争取在保障食品安全与质量控制的领域贡献自己的力量。
2022级食品营养与健康二班石岩同学:在华测检测参与食品微生物检测实习的这段日子,是将理论知识与实践深度融合的宝贵历程。从6月16日到7月11日 ,围绕食品微生物检测的全流程,我沉浸式参与了样品管理、无菌操作、培养基制备、灭菌处理、微生物观察与培养等核心工作,在实操中逐步掌握专业技能,也对食品质量安全保障体系有了深刻认知。这次实习,是一段充实且意义深远的经历。从基础操作到核心流程,从技能提升到意识重塑,我在实践中完成了对食品微生物检测工作的深度认知。这段经历,不仅为我职业发展筑牢基础,更让我坚定守护食品安全的信念,未来,我将带着实习收获,在食品质量安全领域稳步前行,用专业能力为食品安全保驾护航。
2022级食品营养与健康一班邱治宾同学:实习期间,我主要参与了样品称量、样品提取净化等工作,并完整的参与了苯并芘、果葡蔗麦乳、
环己基氨基磺酸钠(甜蜜素)的检测过程,充分了解了食品检测的过程以及检测标准。华测检测严格遵循国家标准和行业规范的操作流程、先进的仪器设备以及实验人员一丝不苟的工作态度,让我真切体会到"数据就是生命线”的含义,明白了每一份检测报告背后所承载的责任与公信力。通过这次实习,我不仅学习了超声提取、固相萃取(SPE)、氮吹浓缩等关键技术,更重要的是培养了严谨细致、实事求是的工作态度并提高了解决实际问题的能力。我深刻认识到检测工作在保障食品安全中的关键作用,也看到了自身理论知识与实践应用之间的差距,为我之后的学习和实践指明了方向。感谢华测检测提供的平台和部门老师以及同事们的悉心指导,这次实习对我来说收获颇丰。这段经历不仅让我深刻理解了科学规范的样品前处理,同时可以将自己的专业知识融入到实践当中。
2022级食品营养与健康二班毕振宇同学:在华测参与食物中灰分检测的这段时间,让我对“严谨”有了更具体的感知。灰分检测的核心是通过灼烧去除有机物,留存无机物称量,步骤虽不复杂,却处处考验耐心与细致。这段时间里,我处理过谷物、肉类、果蔬等不同样品,看着它们在高温下褪去有机物,留下灰白色的残留物,我逐渐明白:这小小的灰分数值,关联着食物的加工工艺与营养品质。老师们对待每一份样品的专注,让我明白检测的严谨从不是口号。这段经历让我懂得,所谓专业,就是在重复的流程中保持专注,在细微的误差里坚守标准。这份对精准的执着,将成为我在未来职业路上的重要底色。
编辑/张雨 审核/李家寅 签发/张剑